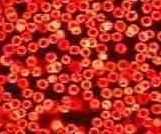
© Copyright Adams Brian D & Biology.touchspin.com - All Rights Reserved flu prevention blood

Alas!
even the
'bio-available' supplements &
exorbitant super foods are grossly inadequate & hence avoidable. Save all
your expenses on them, no to mention those petroleum-derived liver-damaging
multi-vitamins.
Preempt all
drugs & chuck those popular 'health' foods troubling you with
insalubrious microvita. Vibe with energy & maximal life-extension with this
simple
practical yum diet that also saves you time & effort!
Want to halve your food bills as well, while getting atleast 5 times more of REAL
nutrition including Nucleic acids, Gold, Kinetin, the Superconductive 'manna',
etc.?
Even if you get
them, they go un-/under-/mis- used, unless you follow neo-scientific principles.
For once, get the full complement of over 120
personalized nutrients to nourish your entire psycho-biology with
22+ Vitamins, 35+ Macros, 28+ Phytos & 35+ Oligo-elements.
You have been missing out on atleast a third of them!
And, on an average, you ideally need approximately 5 times more of many of the nutrients
that you do manage to get presently.”
More than we know, our diet
modulates
how we think & feel everyday, ie all expressions of our life. What
are your options thence?
| Does Your Current Diet... |
MicroVita SuperDiet™ |
All other diets |
| Maximizes your "Worthy
Microvita" Intake? |
 |
 |
| Minimizes unworthy microvita already festering
inside? |
 |
 |
| Covers the entire range of 120+ nutrients
needed by your body? |
+ the undiscovered ones. |
 |
Provides all the nutrients in sufficient quantity?
(About 9 times more than any unnecessarily cooked diet & ~5 times more than a typical raw diet) |
 |
 |
| Caters all the nutrients in
counter-balanced proportion to each other? |
 |
 |
| Flexibly personalize & localize for you? |
 |
 |
|
Based on your entire microvita makeup.
Other profiling systems are based only on a limited part of you
(e.g. blood, genes, metabolism etc) |
| Present the nutrients to you in their most basic (easiest to digest) form? |
 |
 |
| Rely solely on fresh natural whole foods with live enzymes? |
 |
? Few do. |
| Be organic, yet cost less than non-organic foods? |
 |
 |
| Rejuvenates each & every organ-system of your body? |
- Each & every cell & cell organelles including Stem cells & DNA
- From blood to the brain;
- Joints, heart, liver, kidney, hormones, gonads...
you name it.
|
 |
| Counters / mitigates most health challenges while still being
delicious as per your taste buds? |
Almost everything from :
- Weight-loss to Cancer;
- Skin & Eyes to Hair & Digestion;
- the commonest to the unknown.
- Self-Immunity to Lethargy
|
 |
| Enhances your Longevity? |
 |
 |
| Promote psychological salubrity? |
All areas from real success to harmonious relationships. |
 |
| Brings out your holistic best while expediting self-growth? |
Ontoward attaining your highest thanks to the Focussed Osmosis technique besides the 7 Leverage of Nutritional Alchemy. |
 |
| Saves you time, money & effort? |
Fast, easy, simple, practical. No counting calories & measuring portions. |
 |
Stand the test of time?
Is it really future-proof, even in the face of 'fast-moving' contemporary science? |
Timeless because it's based on the very fabric of our life : multivariate enigmatic
microvita. |
? Most of them are passing fads! |
...most of all,
effective. Pratik's
method is simple to understand, easy to follow and most of all,
effective.
VersaCreations.net
In short it's about better managing the incalculable microvita variants entering
& making up your body-mind complex. For freë inputs about that, enter your email
address below because all microvita formations entering you via your mouth
may well be for your highest good, given your situation & preferences:
The opportunity to upgrade your meals to MicroVita SuperDiet™ will also be
presented in due course. Signing up below is the only way to do that:
|
|
You
may discontinue anytime. Your
email address will be discarded immediately. Privacy
policy
|
|
Dear Health Enthusiast

xcuse
me the impertinence but aren't you being shortchanged by all the
short-sighted & incomplete, usually farcical expert-advice about
fulfilling your basic health aspirations?
Really? What's this microvita thingy?
... That's a generic term for the elusive
functional units of all expressions
of life physical & beyond as disclosed in the "
Mysterious MicroVita"
presentation above.
One of the imports of the
"microvita examples"
video is that, our feelings & thinkings are also made-up
of 2 types of
particles, like our mortal body, though super-physical.
Many of these enter through our foods & thus, everything you eat influences all
aspects of your being - from
intelligence & productivity to self-control & development of other
faculties - in a direct though subtle fashion.
Your entire
self-expression today & the blossoming of
your personality tomorrow is constrained by
.... the last meal you had! And
all
the ones before that.All food is somato-psychic.
Huh?!... Can we have something more
scientific please?Sure! Let me
explain. Their
sub-microscopic conglomerations have
already been discovered independently at different times by
pioneering researchers who were ahead of their times.
They described their observations in their
own terms but nobody had the big-picture. Because of this &
other
reasons
(dogmatism, politics, profiteering) it didn't make it to main-stream academia.
The fact remains, the sub-quantum
microvita animate ALL
life. And
by the benefits that
accrue to you over time, will you know the efficacy of
MicroVita SuperDiet™. What can be more scientific than that for you?
:-/
But
where do they come from into the foods?
From the unexplored
frontiers of nature; That's why few of us know enough to craft our menu so that it
serves not only our body but also the rest of us, in toto.
But some keen observers have started discerning
that psychological satisfaction is generally the driving motivation behind most of the health products, not so much the physical benefits, if any.
Worse
still, many of these healthful potions are directly or indirectly complicit, atleast partially, in most of
our life-challenges.
Is swallowing supplements
& superfoods to whitewash the guilt of unwise lunches & dinners, is even half-way
as good as compared to
what nature originally provided for us, even if you
take the best health products put together.
I have also been
on the receiving side of these make-believes. Ignorance is bliss. Not the repercussions though.
Haven't you ever wondered what constitutes COMPLETE nutrition
so as to meet your current health goals once & for all?
How many nutrients do we all really need?
What's the
ideal range?
What
about the unknown, undiscovered ones?
If we trace back history, you
may recollect that it all started with the
multi-vitamins mad-rush... though, many people, are
yet to discover Vitamins P, T,
U, Q... & the
list
continues
to grow.
In the meantime many learnt about the importance of
anti-oxidants, phyto- nutrients etc. (Pycnogenol,
Isothiocynates,
Phytosterols, Polyphenols, Sulphoraphane ...)
I am sure you must have heard of
Galactomannans,
Astaxanthin, Malic
acid, Saponins etc... &
what about
Alpha-lipoic acid, Indoles, Inositol hexophosphate,
Kinetin, Chrysin & Chlorophyllin
(not
chlorophyll)?
What struck me was -
- How long will this wild-goose-chase
of 'breakthrough discoveries' go on, with no convincing results in sight?
- Is
there any way to cut through the
chase & be at the top of it all, at once?
- I got intrigued by certain mysterious culinary practices of some
long-standing traditions...
- So on & so forth.
"Pratik’s information is priceless... "
"...there are so many treasures in these books, information on raw foods, sprouting, nutritional alchemy, natural health, the truth about the sun and its effects on our well being, and so much more.
If you’re interested in taking your health to the next level and beyond then these books are for you"
Personal Health Coach
raw-foods-diet-center.com
By now you may have already progressed to appreciate
merits of mineralization. But how much
& in what
format? (There's more to the ocean milk extravaganza).
More & more trace minerals are getting added to the "required"
list year by year while even more trace minerals are getting
recognized as "probably useful".
These include -
Boron, Cobalt,
Chromium, Germanium, Lithium, Molybdenum, Silicon,
Vanadium, Bromine, Rubidium, Strontium... & many other's, some of which carry a halo of mysticism around them - they sound
"too good to be true".
With that being the status of the nutritional market, shall we
see their doing under your skin amongst your microvita-built
flesh-&-bones:
Perils
of Supplement Mania :
- Apparently, the urban sewage systems of 1st world cities, get tons of
multivitamin tablets as
most of them do not even disintegrate in your tummies. Amusingly, some of them
still have their brand name, readable. [5, 6]
"The Physician's Desk Reference (page 1542) shows that
vitamins and minerals in a pill form are only 10 to 20% absorbed by the
body.
That means for every $100 you are spending on nutrients, you are
literally flushing about $90 of it down the toilet...
[7]
According to the National Advisory Board, 100 mg consumed in a tablet
form translates to a minute stabilized 8.3 mg concentration in the
blood." [8]
- Even if you go for softgels, capsules, liquid solutions etc., the nutrients are thrown together in arbitrary wrong proportions
with respect to each other
[9].
The only way to
ensure concord amongst them, is to get them in the form of natural foods because that's where they
evidently work & play together
supporting the cellular life within that living organism. [10]
- Artificial vitamins, even if not straightaway rejected by your body, are
pathetically deficient in performance. [1, 11]
It's not just the dead superficial physical molecule which your body wants, but the entire multi-dimensional
microvita-dense living structure of
a similar molecule - but now functionally active in an alive food.
- Imbalances caused by your supplements further exaggerate the subclinical (i.e. undetected, undiagnosed) excesses &
deficiencies in your body. Stealthily, your health continues to degrade.
For e.g. Several
alarming incidences of liver damage have been reported
[31]
amongst those who used to gorge muti-vitamin pills.
All pills cause ills; which simply kills.
- The most common source of raw material for multivitamins are the coal tar
byproducts of petroleum refineries. [9]
Other sources include sewage (vitamin B12), powdered rocks (minerals),
wood pulp, animal byproducts, lab production, etc., anything but alive
[1]
- All of them are contaminated with chemicals used in
their processing & production.
Thus even the natural 'bio-available' supplements are Partially harmful, because of
these toxic stuff. Examples include -
-
Synthetic dyes - FD&C Red, Yellow, Blue etc
-
Magnesium stearate / stearic acid (chalk powder)
-
Talc
-
Titanium dioxide - toxic metal additive implicated in autoimmune
disorders & cancer
-
Artificial flavors
-
Aspartate compounds (used for certain minerals)
-
Carrageenan - additive
-
Hydrogenated vegetable oil (trans fat)
-
Artificial sweetener - Aspartame
-
Coatings &
other unnatural excipients. The manufacturers are not legally
obliged to declare
all of them in their list of ingredients. [13]
- Some supplements are deliberately adulterated with pharmaceutical
compounds (e.g. steroids) to show 'results'. This is not
uncommon in weight-loss, bodybuilding, sexual enhancements, sports performance (ergogenic)
products, etc. [12, 14]
- ConsumerLab.com, an independent testing service provider, reports
that the claimed & actual amounts do not match in over 30% of Supplements. Many Exceeded Tolerable Intake Limits
(RDA).
[15]
-
The side-effects of multivitamins include problems related to your immune system,
nerves, stomach,
hyperactivity in kids,
etc.
[16, 17]
-
Paradoxically, they also hinder the absorption of nutrients from your regular food sources
(even the usable ones within the pill itself) by forming a bio-film layer of barrier along the
walls of your intestine. [18]
Exotic Superfoods?
Let's get real.
- Have these superfoods ever provided as much real benefit as their price-tag & claims?
[19, 20]
- Just the act of dehydrating them makes a much bigger difference than
we fully understand, because the water in them is an integral
part of their life, as you may have seen in
the 'microvita examples' presentation.
- All of them have synthetic fillers, binders, flavors and other
manmade ingredients used / needed to bundle them together into a
consumable form with an extended shelf-life. These are not always
declared in the list of contents.
[21]
- Many of them do provide lotsa good-stuff; but in lack of other nutrients & without
tackling the root cause of your health issues (including those you may not yet be aware of): [22]
- can
you fully utilize & sustain the gains made with a superfood?
- some of the good-stuff from the superfood is likely getting used
by the negative microvita colonizing your body. You are feeding your
enemies.
Technological
miracles :
- "Scientifically backed"...
You mean commercially prostituted science? [23]
going by the number of clinical trials which are biased right from
the start [24] - in terms of the parameters being scrutinized
[25] & the way
they are deliberately or otherwise (mis)interpreted [27] for
pubic consumption.
Not to talk about selective outcome reporting [26], the
business-interests funding it
[28] & entirely folly premises
under which many of them are designed [29].
Their
holy grail is to conjure proprietary products
or drugs which their stressed-out consumers will get hooked to &
will be forced to buy again & again.
- "Patent-pending ..." means it could not get a patent because it was
not quite patentable.
Old trick.
- "This technology makes the nutrient more absorbable... "
Nature already provides everything in an easily consumable form with little
or no
effort from us (for e.g. limited cooking, selective pickling, etc). Trying to outsmart billions of years of evolution is
almost always counter-life.
[30]
.............
So with nature being the only reliable & most viable source, is there a
practical-economical way, for it to nutrify us optimally with all that we need & the way we need it?
To complete that jigsaw puzzle we'll have to start with the 2nd part of that question. Let's consider minerals for instance.
How do we
reintroduce them into our food-chain in a bio-available
form?
We can hardly eat mineral ores directly, right? We need the plant
kingdom to make them 'organic'. But since they have all been long
missing from our soils,
And with all our farmlands pillaged due to intensive farming &
over commercialization, the poor plant's also have no access to them anymore, even in organic farming.
Btw, what really do plants do to make all the minerals bio-available?
They incorporate them in
microvita-driven molecules.
The microvitum (singular) in the minerals also play an active role
in this inner game of life; of weaving progressively larger life-forms as per the
plants needs.
Do
sneak peak at their inner workings
as shared for free with the 'microvita super-health' online
community.
But what's the point? Is that a big deal?
Emm...
Well, did you ever ponder
why
is it that you eat whatever you do eat & whichever way you like to
do it?
Isn't personal preferences influenced by
socio-cultural conditioning the major determining factor?
Some of that doesn't exactly has much to do with nutrition, isn't
it. Granted we are adept at justifying our tongue / heart - driven
proclivities in terms of "convincing" logic - for e.g. the epical
vegetarian versus non-vegetarian debate ...
...but at the end of the day don't we know it in the heart of our
heart that some of them are half / stretched truths & that verity
spans both sides of the fence?
Which side we stand depends on our own gustatory likings / sentient
feelings hiding behind the garment of intelligent reasoning.
Tail wagging
the dog?
On the other hand, urban legends about what's healthy are as
fickle as
the vain fashion trends, thanks but no-thanks to the
business-driven "latest
nutritional research".
But I was luckier... having practiced inner-work
daily since Feb 2001, I have accumulated enough experiences &
results to make certain bold claims.
These are empty assertions unless they add towards making
the system worth a good try.
Logic is Not the God here - just one of
the tools I use alongwith other more reliable avenues to steer myself.
These include intuitive leads, self-experimentation & ongoing counsel from some primo sources,
who must be credited.
Their contributions are purely altruistic, while this endeavor of mine is
to fuel further research for our mutual benefit. Along the way, follies, if any, would be mine. And credit
for all success would rightfully be attributed to them.
I'll also do my best to present everything as logically as as
possible. Shall we start with the 1st incident pertaining nutrition,
which sparked off this part of my expedition?
This is an immediately useful way to debut the enigmatic field of microvita-centric
applications. In the year 2000, I visited a 'holistic fair' where I
got accosted by a nutritionist... for an on-the-spot blood test:
 Your
Blood right Now!
|
My blood right now :) |
Everybody knows this gimmick these days.
Jump
further
ahead to unravel what microvita has to do with all
this! For the uninitiated, the
red
'discs' in these pics are
our Red Blood Cells (RBCs).
In my
1st test all of 'em looked terribly bunched up.
The
second
test was 1.5 hours after popping-in 3
enzyme capsules which the
sales girl was pitching for. As you can
see in the 2nd picture - they were miraculously set free. Anyone can reproduce
these results with a microscope & slides.
Just to allay any doubts, I was 'externally' in great shape
otherwise & didn't had
any
health
issues at the time of these tests. And my blood-drops were directly put
on the slide under the
microscope, right before my eyes, without adding anything.
I know that besides enzyme-pill pushers, the
alkaline water & berry
juice sellers,
amongst
others (EFT etc.), also proffer a
solution to this - but for reasons presented in the home page
- they All are palliatives ignoring the root cause!
Anyways,
this
is
how bad everybody's blood is these days.
Does that hint at why & how so many diseases have been
creeping within most people's bodies though heavy symptoms attack
much later.
"The blood is endowed with a life of its own. Coagulation is often
regarded as the last act of life, as the death of the blood." - Henle
Besides the afflictions pilloried in the headline of
this page, other common ones are :-
- lack of stamina & weakness
- hormonal imbalances
- emotional & mental instabilities
- premature aging, etc.
This 'bloody' evidence was too gory to ignore...
But I walked away skeptically without buying any of her multi-enzymes; though
perplexed that something was seriously amiss!
I couldn't
entertain the idea of
having to
depend on a daily fix of pricey
enzyme
capsules for the rest of my life just to keep my blood flowing. The creator couldn't have
designed such a faulty machinery I reasoned!
Information
You Have Provided... Filling In A Lot Of Holes For Me"
"I
appear to question things the same way you do... The book ... did fill
in some areas that I had
questions about. I
have been researching alternative health for the past two years and
I must say that the information you have provided seems to be filling
in a lot of holes
for me."
<lindazonline at opt online dot
net>
But I was shaken and ran to do some due-diligence to draw my own
conclusions about this misadventure. And I
found that the nutritionist was
right! Well... almost; just
that she
gave me half the perspective; the part that served
her well.
Fair enough. But
that led to a series of epiphanies especially after I started full-time research
into nutrition since June 2007.
Can there be a generic ideal
diet for anyone, anywhere, anytime, any-budget leveraging
on the very mechanism of life itself vis-a-vis versatile
microvita -
the divine sparks of life?
Let's
start with the basics 1st
: All food reaches wherever it does through our blood. So
after the digestive system, it is the 1st one to get impacted.
And thereafter the consequences keep on cascading to the rest of our
bodies.
The
digestive tragedy is laid bare
in the 'Vedic
Secret to
Longevity & Youthfulness' scripture (just kidding). As for
the circulatory system, all our RBCs & the blood
vessel walls have a negative
charge on their
surface.
It's called the zeta potential & the resulting
electrostatic repulsive
forces between them keeps them apart & functional.
Before
progressing to other organ systems shall we spy on our blood
1st?
What's
the hourly impact on You of this RBC
coagulation?
- Poor
oxygenation * ...
- Compromised
Waste
disposal
*...
- Fatigue
&
Lethargy *...
- Ischemia (localized anaemia)
/ Vague
pains *...
- pH
Imbalance *...
- Kidney
stones*...
- Slackened Homeostasis
*...
Etc.
"Unique
and
Refreshing"
Pratik
is knowledgeable and enthusiastic about his stuff. His
willingness to share all that he knows and his ability to generate
excitement is unique and refreshing.
calvinwarr.com
Why are Your RBCs stuck-up like a deck of coins?
I was shocked when the nutritionist told me matter-of-fact
ly
that
the sole
culprit behind our blood cells sticking together is ...
our
food..
Now, at that time I had a 'healthy' diet & lifestyle
with
lots of veggies & fruits, less non-veg & no
processed foods. So it was puzzling to be told
that my food was at fault.
Some basic research solved that riddle. It's related to
tragic annihilation of certain made-by-microvita molecules as
we'll
see later as part
of the launch.
But not just that, several studies have revealed a direct correlation
between this persistent "blood-curdling" & about
64
common diseases
like :-
- Multiple Chronic Nutritional
& Good-microvita Deficiencies.
- Obesity
*...
- Hypertension,
Cardiovascular
diseases, Stroke *...
- Gall-bladder
stones *...
- Diabetes *...
- Cancer *...
- Sexual
problems *...
- Eyesight
degeneration *...
- Weakened
Defense System *...
- Slow Wound-healing *...
- Teeth
& Gum disorders
*...
- Chronic
Constipation *...
- Stomach
pain *...
- Sciatica
*...
- Back
pain *...
- Allergies
*...
- Asthma
*...
- Cardiac
irregularities *...
- Liver
problems *...
- Chronic
Fatigue syndrome *...
- Nervous System disorders
*...
- Senility,
Alzheimer's
& Mental illnesses *...
- Skin
rashes *...
- Balding,
Graying & Thinning
of Hair * ...
And several other problems or which this is one of the causes.
* Join the free MicroVita SuperHealth community for
explanations
"Good Way To Encourage Our
Students"
During
our Healthy Life Style Week last year, we invited Mr Pratik S.
to our school to promote healthy eating through sprouting of
different types of beans.
This is a good
way to encourage our students
to take vegetables through sprouting at home. It also help students to
be more aware of the food they take and how to live a healthier
lifestyle.
Kuo Chuan Presbyterian Secondary School,
Singapore
<ten_
leu_ jaw at moe.edu. sg>
"Well,
if the situation inside of us is so grim
then everyone would have already known
about it...
Doctors would be warning us & the
mass-media would be screaming hoarse" You may wonder.
I had the same
questions as well -
- I
think we "don't feel anything
wrong" just like a live frog can be boiled
to death slowly, without it realizing the perfidy.
- In
the meantime every organ in your
body does it's best to fight back - for e.g. excretory system
(liver, kidneys etc) is continually overworked
trying to get rid of whatever impurities it can.
- There
are other ways as well by which your body "buys time" by maintaining some level
of workability. Unfortunately they are all unsustainable compromises.
- The
inevitable
consequences pileup very slowly over decades before the symptoms become
obvious (you know these diseases, don't you?).
- Since
everybody else is also suffering
- we prefer to call it 'old age' (You suspect business interests also playing
their part in
shaping this perception?)
If you still have any doubts then tell me :
- How
many of us are ok with our daily performance, bio-physically?
- Hormone secretion, digestion,
circulation, brain-nerves, excretion, joints, germ-defense, energetics...
is your body functioning satisfactorily?
- Do
you feel happy with all facets of your health?
- Is there any room for advancement in your dietary lifestyle?
If you are what you digest, then you can definitely be much more!
"Many
Thanks"
Many
thanks Mr. Pratik, you
are truly a God sent.
Many blessings to you.
(parent of an
autistic child)
<baujelee at gmail
com>
Our
dietary life-style needs to be consistent with who we aspire to be.
For e.g. common speed-breakers in the race of life (ailments, self-management, etc.) significantly accrue from a daily onslaught of a diet which
is largely denuded of active & +ive microvita.
The dead ones invite more of other kinds of
-ive microvita; snow-ball effect especially visible after middle-age. To
beat them back, here's the essence of my all-out exploits over 1.5
years:
Keys to
Super-Nutrition : -
- Somato-psychic
classification of foods : Different
foods
provide
different kind of microvita - some microvita
are life-supporting while other's are life-destroying.
We can make good use of some of the destructive microvita as well, as
long as we know enough about their biological interactions.
- Psycho-somatic
classification of people : Our physical,
emotional & mental characteristics vary due to our microvita heterogeneity.
This variance make's "one man's food, another man's poison" (even if they are
twins).
- Facilitating
fertile grounds for the most appropriate microvita to grow & multiply is the only
material requirement for maximizing health & happiness - physical & sublime.
In this holy grail, the role of what you ate today is paramount.
- There is no alternative to maintaining an extensive library of
all the different kinds of molecules & atoms we regularly need -
- An example of this is your personal resource bank of various types of minerals.
They are all
unique permutations & combinations of multiple strains of microvita + type 3 particles; as we
differentiated in the "Distinguishing
Microvita" presentation.
- They inter-play, synergistically or antagonistically with each other, &
with other nutrients
- All ailments can be dissected in terms of complex microvita imbalances (nutrients/
non-nutrients, atoms/ molecules, builders/ destroyers, active/
passive...)
- Most people have multiple microvita deficiencies. Each deficiency usually involves a related
family of minerals & nutrients.
They go unnoticed all the time because they don't
cause any
starkly severe problems in the short-term; for e.g. instant pain.
And so a
punter who bawls "Take Vitamin C" Or some other isolated nutrient Or their man-made mixtures, desperately needs all the
17+
nutrients for proper functioning of their brain.
So do those lapping up such mis-advice!
- Some
elements & molecules are specially endowed Or can be specially configured to
perform
specific wonders,
when introduced in the right place, at the right time & in the right amount. For e.g.
- their
tissue-regenerative
power helped a child regrow
part of his hopelessly smashed fingers, in one case.
- their inherent microvita makeup can correct gene mutations (e.g.
turning-off the cancer gene).
There are many other applications,
less-known though.
Because of a lack of a neo-scientific framework, they usually go wasted /
under-used / harmfully applied.
- We
need microvita of all the
different grades - subtle to gross.
The life within us is a result of all of them dancing synchronously.
For e.g. there is
a distinct variance in the density of sub-quarks,
electron-positrons & photons between different kinds of foods.
- Sufficiency
in all the requisite types of microvita is the sole
way to protect yourself from
or reverse the root causes of a disease or disorder.
For example - Arthritis,
knee/ hip joint problems,
osteoporosis
etc.:-
They are all due to mix-ups on many of the above counts typically - nutrition
drought, toxin hegemony, untoward microvita, etc.
Calcium supplementation has very limited
impact because it gets diverted towards neutralizing blood
acidosis (& leaves behind kidney stones).
And if one is cleverly pushing the pH up (with alkaline water, etc.) then the
bones formed will be brittle & weak. Why?
Because over 50
nutrients are needed, in line with the above mentioned criterion, if you want
to
rebuild sturdy tendons,
ligaments, bone-structure & lubricating fluids
in the joints.
This is exactly the reason why Glucosamine, Chondroitin & MSM, even alongwith
well calibrated group of nutrients, hasn't helped much either, in the long
term.
Similarly ALL ailments can be attributed to a violation
of one or more of the above principles.
- Life
sustains itself by a continual consumption & utilization of all these umpteen
varieties of microvita; Let's respect that by -
- conserving the useful ones which are already a part of our existence.
- making
the best use of whatever we have.
- acquiring more of them, in the right way, as & when needed
- broadening our sources so as to obtain all others as well.
- stalling the entry of unwanted microvita forms as much as practically possible.
And the sanguine microvita allowed in will do their job.
Implementing
the
above
principles in my life
led
to the formulation of arguably the
most
advanced & only complete nutritional system ever. I am game to be challenged on that.
Presenting ...
- Find
out & follow the basic
principles of Nutritional Self- Alchemy. (Chapter
1)
- Better appreciate & work around the ultimate
physical cause of ALL diseases. (No, we are not parroting 'acidic milieu'
here; that's passé. Get the whole scoop in Chapter 2)
- Revealed
: the 1
fundamental cure for all diseases. (Again,
not pontificating about alkaline diet.
This insight alone is worth
1000 times the investment in the entire package. You will agree once you
have benefitted from this mechanism. (Chapter
2)
- Correctly source over
120 unique nutrients including special ones like Vitamin P, Q, T, U; Carnitine,
Isothiocynates, Kinetin,
Inositol hexophosphate, Galactomannans, Astaxanthin, Lauric acid,
Chrysin, Chlorophyllin (not chlorophyll), Malic acid, Alpha-lipoic acid, Phytosterols,
Indoles, etc. (Chapters 3 to 8)
- A proto-secret to keep your chromosomes
impeccable & streamline cellular
energy production. I bet this is not the case for
you right now. (Chapter 8)
- Obtain
all the 30+ oligo-elements most
of us miss-out on
& 15
easy ways to get all of them naturally.
When was the last time you supplemented
Boron, Cobalt, Chromium, Germanium, Lithium, Molybdenum, Silicon,
Vanadium, Bromine, Rubidium, Strontium etc in a fresh & live bio-available
form? (Leverage 5,
6
& 7)
- Are
most people stuck with just a
fraction of their full DNA potential? Harness the most absorbable sources
of nucleic acids as your 1st step up. (Chapters 9)
- Discover
the 4
safest ways to take in precious
metals for self-alchemy including
my own innovative approach. (Chapter 7)
Instead of benefitting, they'll injure you by strengthening the
negative microvita within you, if not incorporated properly.
- Avoid the pitfalls in making this natural antiseptic
work for you. If used
neo-scientifically, it'll kill all your parasites including new viruses
in future. No side-effects (Appendix)
- How much more is bio-physically possible with the
mystical superconducting elements (Rhodium, Ruthenium, etc)? And the 3
most effective ways
to sneak them in, regularly.
Heck, 2 of them are darn free. They were the ones referred to as manna,
'Egyptian right of passage', etc. by the learned ancients (Chapter
8)
- How
to deploy the 3 foundational
neo-scientific principles to align your psycho-physical
wellbeing, while
accelerating material
& psycho-spiritual
progress. (Leverage 1)
- Wouldn't
you rather go with the most
comprehensive nutritional profiling system which takes into
account your entire microvita-operative self? This isn't another
one-size-fits-all babble. (Leverage 2)
It precludes determining which foodstuffs are most suitable for you
as per your individual biochemical constitution.
- An average breakfast-lunch-dinner usually dirties & weakens
your etheric layer. This is the most common & biggest operational
impediment in faster churning of
your chakras / etheric vortexes.
(Chapter 2)
Without that, your latent faculties like sharper
intuition, creative manifestation, etc. will remain stifled & he/
she will never be fully successful.
Any vigorous attempts to awaken them will burn
some of these undesirable chunks in their etheric layer. This
produces insidious repercussions which may not be visible
straightaway.
- How
foods affect our mind
& emotions, career, personality
traits & behavioral tendencies. Grab your handy
reference chart & let them work for your total good, daily. ( Chapter 3 )
- Practical guidelines which
for the 1st time bring together ALL the varied aspects of physical
nutrition covered from ALL angles. Blossom fully.
- An
affordable, easy system
that boosts vibrancy,
self-control & consonance to let more of your very best
shine through.
- Build your own detailed master-list
of ALL the food sources which together provide each & every nutrient (Chapter 9)
mandatory for sound functioning of
all your organs
(glands, brain, skin, teeth, joints, heart, etc).
These 7 critical dietary components together provide ALL the resources,
including unknown, less known, under-used & misapplied ones. Do
them right & they'll nutritionally fine-tune your body-mind-soul par-excellence.
"Wow! how interesting..."
<boeyym at surbana dot com>
Save time, effort & energy as compared to your present routine with this
fresh
culturally-agnostic take on our eating habits & predilections.
It gently secedes all that doesn't fully work.
Is it possible to
bring the entire army of neo-scientifically selected bio-physical microvita operatives, accessories & intermediaries
(long-since deficient in your morsels) within the menu of a single
doable diet plan?
For e.g. foods concentrated with a wide array of micro-balanced microvita:
- enzymes, proenzymes, coenzymes
- vitamins
& provitamins
- hormone- & steroid precursors
- growth factors, phyto-chemicals & other active bio-molecules
- biochemically counterpoised minerals / bio-atoms
- bio-etheric, bio-photonic & other biologically operational subtler forms?
You need all of them. If you feel so & can see yourself gaining
a little bit from these, then you may want
to...
By now you may have an inkling of the life-long payoffs versus the unavoidable perils of not
- preferring a microvita-rich diet
- being choosy with regards to the nature of ingested microvita
- personalizing it to your own microvita-operative substructure
- blocking the unwanted ones from your menus
- targeting the entire range (120+ nutrients), optimum quantity (~7 times more
than your present supplies) & their mutual proportions etc. etc.
With that in view perhaps by now you may have
sensed some
level of
motivation to probably consider the remote possibility of actually
taking the trouble to go all the way & reinvent your
already-healthy diet
...
...sometime in
future
when you
really need
it.
Wow!
You sound unstoppable.
Here's the FAQ for those who
may not be feeling the
same enthusiasm in this moment-of-choice..
Hmm...
So are the 7
Leverages
of Nutritional Alchemy all I need?
After making such a hue & cry about what to eat, I am
here to
tell you that, while great food gives great health, consummate health results
only in their symphony with your subtler microvita formations.

|
Does the microvita hypothesis engender a formulaic way to
self-engineer your best health
possible?
I ain't there ofcourse, but tagging along a
few exceptional ones who do. And have received some boast-worthy blessings myself, in
trust. |

|
Inspite of our best efforts some level of shortfalls & mismatches are
unavoidable, in a real world. Is there a usable way to mitigate them? |

|
Are you unwittingly enduring any of the
45 common woes directly involving sun deprivation? |
 |
Is light just meant for vision?
What about those peculiar light-sensitive cells which are hiding
somewhere other than your eyes. |

|
And
what about ordinary folks partly
subsisting on just light, air & water? Since May 2009, I have been doing
well with ~2 meals / day with optimum energy levels while maintaining my weight. |
Introducing ....

Roll-up your sleeves once you are prepared to equip yourself with:
- 8 Pivotal
Keys to the entire
morphogenic process : All 8 pieces are inter-connected & hence
applying them together multiplies their power towards faster
betterment of your body & psyche : Chapter 6
They will also build your capacity to live more & more on sunlight, breath
& water
(solarian morphogenesis), but only if you are so willing.
Otherwise, you'll still get all the other benefits except for the reduction in the
amount of physical food you need to eat to keep your body going. It
took me over 12 months to reach the present stage.
- The
canonical equation of life
& how to boost the 3 major
supplies of quantum microvita sustaining us every minute :
Chapter 6
- Fascinating
and compelling insights
on the hidden side of Sun with real life examples of people
subsisting merely on sunlight, air & water :
Chapters 6, 7, 8
- What's
the structure, entrance
route & processing centers of our vitality force-waves : Chapter 6
- 5 sure-fire tips to expedite your progress & detailed FAQ on the
ins & outs of the mechanism
derived from my own experience :
Chapter 6
- 5 do's
& don'ts to intensify the vitality of your DNAs while
minimizing their risk of injury: Chapter 8
- The
secretive "focussed
osmosis"
technique to boost your physical, emotional, mental &
spiritual bio-energies by increasing the rate of spin of your etheric plexuses (Chakras) : Chapter 7
- Free yourself from the mammonic fallacies about harsh sun-light.
Fully reap the
unexploited rewards of sensibly imbibing the 3 classes of invisible
particles in solar radiation : Chapter 1
- 11
advantages of methodical solar microvita intake (including
well-behaved immune system). Beware the 45 known consequences of not doing
so (there are several more) : Chapter 2
- 7 eye conditions that
improve with adequate sun exposure : Chapter 3
- 4 types of injuries due to excess-sun & how to fight them off :
Chapter 4
- The real
reason behind sunburn & other UV damages; what constitutes an ideal sunscreen
(nothing to do with SPF - that's for the misguided weaklings)? : Chapter 4
- 6 dangers of common sunscreens (what a scam!) & the only 2
artificial ingredients acceptable in artificial sunscreens :
Chapter 4
- What's wrong with the dietary sources of the sunshine vitamin :
Chapter 3
- 7
holistic DIY sunscreens & 9
nourishing home remedies for sunburn : Chapter 4
- How
light activates the
HQ of your brain (responsible for 11
important functions) : Chapter 3
- How
the body's LIGHT METER
functions; It's 4 contributions to your health & Why ALL
our hormones are ultimately
dependent upon sunlight : Chapter 3
- The
neatest way
to stimulate the master
gland of your body & optimize the minimum of 6 critical
subroutines of your "third-eye" : Chapter 3
- 8
parameters that will help you determine
the correct duration of systematic heliotherapy
& 5 basic guidelines on sun-bathing : Chapter 3
- 3 parts of full
spectrum indoor-lighting + 3
Pointers to stay upbeat during gloomy sunless winters : Chapter 3
- Revealed
- Our inborn ability to transmute
1 chemical element into another : Chapter 5.
- 18
basic "nuclear fusion
& fission" reactions that routinely take place inside our
bodies
- List of 17 elements
involved in this (including the 2 most common agents)
- What
does all this mean? (It means that if your body needs
Iron,
you actually need to give it M____ & If you need Calcium, then
you better take S______ in a natural form.)
"Quite
Mind blowing"
... MicroVita SuperDiet™ package is
very impressive... the
equations
on
innate biological transmutations (in Solarian
Morphogenesis) are quite
mind-blowing ... it's a good investment for lifelong
nutritional support...
Regional Marketing Manager -
Aerospace, France
<albeaum at
yaho o com>
To meet your immediate goals as soon as possible, I am further tightening the offer :
Ride
upon your...
Crash-course
:
Customize the 7 leverages
of
Nutritional
Alchemy
within
8 days flat (8 - 10 hours max), in concordance with your
current circumstances & personal priorities-
Enter your particulars because this is all you need -
Opting in for pertinent information by filling out the text boxes above is the sole route to lay your hands upon MicroVita
SuperDiet™
package which offers -
- '7
Leverages of Nutritional
Alchemy'
-
'A Microvitic Key to Solarian Morphogenesis'
- Daily
email instructions
to get you up to speed with this most advanced & only complete
dietetic system in 8
days straight.
Utilize them for your wellbeing target today, alongwith
supplementary bonuses like:
This ain't another 'herbal medicine' soliloquy!
How much can all the herbs & drugs help your skin, kidney, liver, spleen, blood, joints, brain, DNA, hair,
lungs, muscles, etc. when you are not even neo-scientifically eating the full complement of over 120 nutrients
involved in making & running them?
Medicinal plants alone can never do that. Is that the only problem with them?
- The way they are processed, packaged, transported & stored, causes a significant loss of their life & nutrients.
[1]
- Some of them are Spiked with undeclared Rx drugs or other bogus untested analogs
- for e.g. in expectorants, pain relievers, sleeping aids, mood
enhancers, etc. [2]
- Quality control is another big issue. [3]
- Many of them do render some benefits to us; but how effective
can they be
[4]
in the face of so many complications involved in any
particular disease - from the vaguest to the obscure.
In order to effect a lasting reversal of their
basic root causes, don't you
deserve a comprehensive
plan of action derived from the biochemical ground realities
of your anatomy?
Having said that, this coordinated protocol is only for those who want to do justice to their distressed organs, notwithstanding distractions from others who tamely follow the well-beaten path
of slow death.
If so, then arm yourself with this well-researched
strategy
which applies, not just against currently known ills, but also
valid against unknown or new diseases that will continue
to aggress every few years in the foreseeable future.
Exposed! -
- Queer
nutrients which mysteriously affect
only One side of
your body!
- 25 nutrients whose Excess may be
behind as many as 190 sicknesses!
For e.g.
- Excess Calcium is convicted for 71 miseries
- Excess Vitamin C attributed to 16 sicknesses.
Hence their mindless supplementation actually
hurts you gravely.
- This most popular 'healthy
food' implicated in over 127
illnesses!
- The shameless medical propaganda
that your genes are responsible
for your disease! Meant to steal away your power to live with superior
health.
Orchestrate all the
preventive,
contributive, aggravating & remedial nutritive factors
behind ~400
ailments to rhyme with your intimate microvita song:
Chapter 1 -

|
Nail
down the 6 precise steps on
how to correctly diagnose the excess or deficiency of any of
the ~120 nutrients.
This is crucial because
symptoms of different diseases usually overlap & maybe nondescript.
(For example insomnia may involve over 2 dozen nutrients) |

|
5
steps to alchemical cures |

|
2
unsung but credible ways to mitigate genetic challenges. (What?!) |
Chapter
2 - 74
chronic conditions

|
Are cardiovascular diseases due to high cholesterol / LDL? What about
the minimum of 15 vitamins & 19 minerals your heart muscles & blood
vessels can't do without? |

|
Would you like to get all the
over 35 vitamins, 20 minerals & other nutrients whose dearth
is one of the factors leading on to
joint weakening, arthritis, osteoporosis, back pain, etc?
(move over calcium, glucasamine, hand-full of other commonly pimped
nutrients) |

|
Get armored to tackle any of
the following issues :
- 14
ailments related
to cartilage, tendons, ligaments, spine etc.
- 11
sicknesses of heart & brain,
9 circulatory problems, 5
tumor types,
- 7
concerning insulin (diabetes isn't all
about sugar!)
- 5
related to quality of blood,
- 5 liver & weight challenges, 7 lung
related afflictions
- 10
other miseries (kidney etc).
|
Chapter
3 - 130 common maladies

|
19 Skin
related issues :
Will it help to avail of the 30+ nutrients
you require for healthy, naturally glowing
skin? |

|
6 Hair
related issues : Is your scalp fertile enough to raise a lush crop with all the
26
+nutrients needed by your hair-roots embedded inside? |

|
6 Eye
related issues : Your organ of sight is 'looking' for atleast a dozen
nutrients from you, over & above the much parodied Vitamin A + lutein. |

|
12 Dental issues :
Want to source all the over-15
nutrients needed for lasting teeth & gums?
|

|
22 Digestive
issues |

|
17 Psychological
problems : they can arise purely due to nutritional factors |

|
Infections,
Parasites (48+ nutritives), Allergies,
Toxicity (14 issues)
|

|
9 types of Aches
& pains |

|
10 Muscular
troubles |

|
10 General wellness issues like
the over-35 important nutrients for DNA integrity,
etc. |
Chapter
4 - 28
Gynecological interventions
5
nutrients to boost estrogen,
14 for PMS,
10 for menopause,
12 Nutrients to avoid birth
defects, etc.
Chapter
5 - 12 challenges to
Men's health
18
nutrients for virility & testosterone regulation etc.
Chapter
6 - 22
Children's complaints
28
nutrients for higher IQ & others for
e.g. ADD etc.
Chapter
7 - 8
Old-age problems
A dozen
nutrients each for anti-aging,
Alzheimer's, incontinence, memory, self-confidence, etc. (yes!
our sense of self-assurance has an explicit dietary dependence)
Chapter
8 - 91 Miscellaneous afflictions
Get hold of the long list of nutrients
for your nervous
system, brain functions, glands &
hormones, injuries etc.
Chapter
9 - 37
Uncommon ailments
e.g.
Spleen, Paralysis, HIV, etc.
Chapter 10 - Inhibitors
& supporters for 45 major nutrients.
For e.g.
- Will you do better by sourcing all the 7 vitamins
& 12 minerals, besides 3 other nutrients needed for proper
assimilation of calcium? ...
- ...and
not overindulging in the 4
vitamins, 9 minerals & 17 other factors that inhibit calcium
absorption?
- There are
approximately 5
- 10 synergists
& antagonists for each nutrient. For e.g.-
No matter how much Vitamin E you supplement,
but if any of it's 10 antagonists are in excess or the 10
synergists that help metabolize it are missing from your meals, then actual Vitamin E utilization
would be dismal if
not zilch.
- Their mutual
ratio is also
of import;
For e.g.-
A total of 9 vitamins & 13 minerals must proportionate vis-a-vis Iron, for it to get adequately
metabolized in
the body.
So how do we walk the tight rope spanning so many nutrients?
- Discover
:
- The 8 notorious anti-nutrients
plaguing contemporary lifestyle.
- The 2
significant though unvalued facilitators for proper
mineral absorption
Chapter
11 - Generic inputs on :
- The positive impact of
some diseases & their welcome inevitability in our lifetimes.
- The natural place of pathogenic organisms in our lives.
- 15 pairs of
minerals inhabiting us - they always work in tandem; like a married couple.
- 2 polar groups of minerals
politicking inside us -
one degenerative & other inflammatory, when
excessive.
A lot of nutrients are needed in the right permutations & combination to fight back
any given sickness;
no prescription
medicine or off-the-shelf product can provide them all, the way
they are meant to be eaten along with their synergists
With MicroVita SuperDiet™, you
don't need any of their dosages.
"The Prophylactic Nutriments book is excellent"
I have gotten some
excellent health tips and pointers
out of it.
ecover-dude.com
It took me ~ 2 years
of serendipitous full-time research & self- experimentation
to distill & synthesize the foundational principles of MicroVita SuperDiet™ package.
There is no fixed dietary formula that will deliver the best possible outcomes
to every individual.
But the modular MicroVita SuperDiet™ verily surpasses all outdated & semi-baked
theories
(blood-typing, genetic-typing, zone-diet etc) because it is structured around the
foundational
particles of
our existence.
It's modularity allows it be configured & deployed in congruence with
your singular individuality, location, preferences
& health objectives.
The
MicroVita SuperDiet™ crash-course is soon being made available as
an attractive deal... Once it's ready how do I get hold of you?
It's best for you to
act immediately because
the options available to proceed with the MicroVita
SuperDiet™ crash-course are only shared with those who explicitly express their interest by submitting the contacts
above. ↑
The maximum group size we can currently
accommodate is limited to a maximum of 400
clients only! For them I'll be launching a time-bound promotional
offer in due course.
But before
you enter your contact above, I want you to
understand what the MicroVita SuperDiet™ is NOT,
just so that you know what you are getting into.
MicroVita
Super Diet is NOT :
- a run-of-the-mill, semi-scientific piece-meal diet book that gives inadequate short-term results.
- a magic potion or a phony formula that promises to save the day for you, without
you having to take any meaningful self-directive action.
If these are the kinds of stuff one indulges in, I would advice them to skip
this bargain. As for others...
Click on the "Free Access" button below
after typing their whereabouts so that I can forward the details on
how they can participate in their MicroVita SuperDiet™ crash-course & sustain
their gains long-term:

My privacy policy
"Extensive
& Well
Organized"
As someone
into
metaphysics, I must say that the insights on microvita are
indeed
thrilling & groundbreaking. The 'MicroVita SuperDiet package'
is quite unique, extensive
& well organized with in-depth
material.
Here's
the final
recap before you request for enrollment in the MicroVita SuperDiet™ crash-course
to aim resolutely at your health challenges:
All this & more will be your neo life-style within 8 days from start & you don't have to be a non-conformist to engage
in this.
Those who shudder at the thought of breaking away from the crowd may want to
recognize such over-cautious psychological tendencies are a typical evolutionary
response - an outdated artifact of mental microvita that aided survival in
the past.
"Very informative"
I
was impressed by what you
wrote ... I obviously need to eat more sprouts ... You... have put
together a very
informative piece of work.
<ninaennaji
at yahoo co
uk>
What you must expect, once geared with this
neo-scientific diet:
- noticeable benefits within a month or so. E.g. condition of
skin, digestion, functioning of other sub-optimal organ systems, etc.; as soon as the inner population of life-factors
tilts more in favor of positive ones.
- the severity of symptoms, if any, will generally weaken. E.g. less
pain, better sleep, etc. - as the negative life-factors have less of a
free-play now
- the duration of symptoms, if any, will shorten overtime. E.g.
you'll bounce back faster, etc. - as the positive life-factors have
more of a say now.
- the frequency of symptoms, if any, will decline gradually. E.g. lesser
no. of problems & fewer incidences per quarter. The negative
life-factors are on a defensive now.
- distinct progress; sustained till recovery, if in order. E.g. no more
weak joints, fevers, bouts, downtimes, etc. Let meta-nutrition
take over the reigns of your betterment. Wean off allopathic medications,
if any.
- higher energy level; more active - as the quantum richness
of your regular meals is maximized & biological strain reduced. E.g.
normal weight restored, tiredness gone, etc.
- feel better & greater productivity - alertness,
sharper memory, cognitive performance, happier overall.
Results vary; but are definite, firm & guaranteed - because every thing
you eat & imbibe effects every part of your mind-body set-up : advantageously or
disadvantageously. Assorted less known pitfalls are disclosed next page onwards.
Start from wherever you are right now - 5 fascinating
presentations on this neo-scientific lifestyle await you,
post-submission.
Aiming for overall wellness, instead of getting hung-up on
any unwellness, is one's 1st step & last chance towards making the most out
of their opportunities.
Feel yourself resonating with this confidence, as a prerequisite to staying hale & hearty
for long; to the discomfiture of your allopathic physician.
They may be smart & nice but haven't figured out that
diseases do not strike
due to lack of Rx medicines but shortage of freely available positive microvita. That's
what each symptom begs of you. Want to dig out it's root?
Only the mightier amongst microvita prevail in the end.
You Live.

Pratik Sriv
MicroVita Applied Research |
 |
P.S.
I have done the leg-work & may pass the baton to you.
But only as long as you run your part of the lap.
Otherwise let me know if this isn't the soundest solution you'll
ever came across.
...
I am pleased to tell you that incorporating your ideas, what has been
for me, good
physical,
emotional and spiritual health is now perceptibly better after only three
months!
Doug
Wiskow, Florida, US
<doug wiskow at
g mail com>
REFERENCES :
1.
Natural
Vs. Synthetic Vitamins : How They Are Different and How to Tell Them Apart
2.
The untold dietary supplement scandal
3.
Alerts and
Advisories
4.
Before Taking Vitamin and Mineral Supplements...
5.
Your vitamins : flushed down your toilet
6.
Tons of vitamins removed from sewage
7.
Passing out whole pills without digesting
8.
Daily deaths due to side-effects of allopathic drugs
9.
Vitamin pills scandal
10.
Nutrient synergy : A new paradigm
11.
The Harms Of Synthetic Vitamins
12.
Safety
Alerts for Human Medical Products
13.
Taking Supplements Could be Hazardous to Your Health
14.
US FDA Alerts on Dietary Supplements
15.
Defective supplements that were recalled when exposed
16.
Side effects from food supplements
17.
Diet and Nutrition for lupus as recommended by pathetic allopathy
18.
Food
supplement poisoning
19.
Before Taking Vitamin and Mineral Supplements...
20.
What's Your Body Burden?
21.
Multivitamins cause liver damage
22.
Tons of vitamins removed from sewage
23.
Biased medical science
24.
Reporting bias in medical research - a narrative review
25.
Medical research frauds
26.
Dark Side of Medical Research: Widespread Bias and Omissions
27.
Statistics and Medical Studies
28.
Commercial Bias in Scientific Research
29.
Alerts and
Advisories
30.
The untold dietary supplement scandal
31.
Liver damage lawsuits
"A playful spirit, confident about it's nutritional future"
When that reality dawns upon you ...of being best placed for whatever is
coming your way - today, as you go about your daily din, sure about
imparting the right elementals, over your plates... to your entire self,
as & when it hungers for them.
...& holding that picture, near or sharp,... animating it
...even stepping into the pink of health... happens as softly as
savoring your MicroVita SuperDiet™ ↑